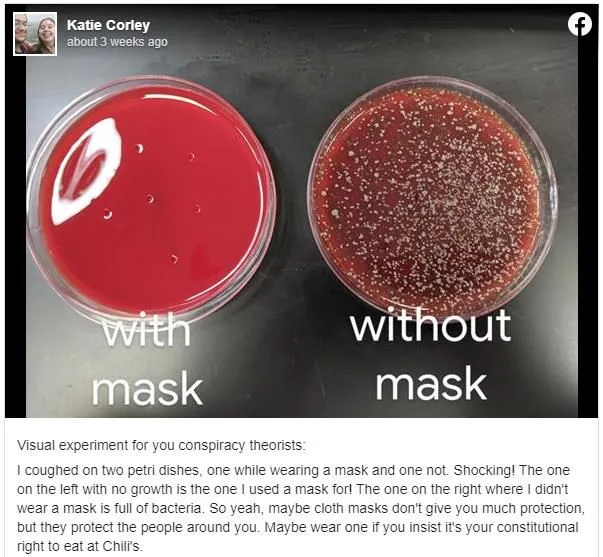
Facebook/Katie Corley © 2020 brilio.net Facebook/Katie Corley © 2020 brilio.net

Brilio.net - Di tengah penyebaran virus corona atau Covid-19, beberapa negara tentunya sudah memberlakukan pembatasan sosial dan meminta setiap orang untuk selalu menjaga kebersihan dan menggunakan masker. Tujuannya agar penyebaran virus corona dapat teratasi dengan cepat.
Banyak yang bertanya, seberapa efektif penggunaan masker dalam mengatasi penyebaran virus corona?
Dilansir brilio.net dari dream.co.id, Kamis (28/5), seorang pengguna Facebook bernama Katie Corley membuat eksperimen kecil yang kemudian menjadi viral di dunia maya. Eksperimen tersebut dibuat untuk menggambarkan keefektifan masker dalam memperkecil kemungkinan virus corona untuk menyebar.
Dalam postingannya, ia membuat eksperimen visual menggunakan dua cawan petri. Dia kemudian batuk di atas kedua cawan petri tersebut dengan memakai dan tidak memakai masker.
Dari hasil eksperimennya terlihat hasil yang cukup menakjubkan, antara cawan petri yang dibatuki saat menggunakan masker dengan yang tidak.
foto: Facebook/Katie Corley
Pada cawan petri yang dibatuki dengan memakai masker terlihat bersih. Sementara cawan petri yang dibatuki tanpa masker, pertumbuhan bakterinya hampir menutupi seluruh permukaan wadah. Namun, seperti yang dikatakan oleh Corley bahwa masker kain memang tidak memberikan perlindungan maksimal. Tapi setidaknya masker kain bisa melindungi orang-orang di sekitar kita.
Postingan Katie Corley terhadap eksperimennya itu mendapat respon positif dari warganet. Mereka kini semakin yakin bahwa masker kain bisa meminimalisir penyebaran virus corona.
Namun tidak sedikit netizen yang mencemooh eksperimen tersebut. Menurut mereka, masker tidak akan bisa membendung virus corona.
Mereka mengatakan ukuran virus jauh lebih kecil daripada bakteri sehingga masih bisa menembus lapisan masker kain.
"Bakteri sangat besar dibandingkan dengan virus. Saya meminta tes ulang menggunakan metodologi yang lebih baik," ujar salah seorang netizen.